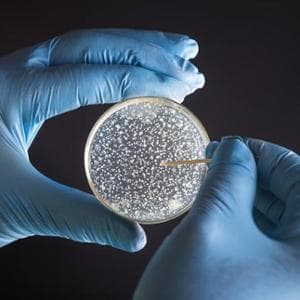
10 antibiyotiğe dirençli 5.000 yıllık bakteri bulundu

Reçete imzalama söz konusu olduğunda doktorun cinsiyeti elbette önemlidir. Ve hastanın durumu da önemli. Üzerine bir çalışma BMC Birinci BasamakToskana Bölgesel Sağlık Ajansı'nın kurumsal faaliyeti kapsamında Floransa Üniversitesi tarafından yürütülen araştırma, kadın doktorların erkek meslektaşlarından daha az antibiyotik yazmakla kalmayıp, aynı zamanda tedavi etmeyi düşündükleri enfeksiyon için en uygun antibiyotikleri reçete ederek, Dünya Sağlık Örgütü'nün önerdiği ilk tercih moleküllere daha sık başvurduklarını gösteriyor. “Gözlemlediğimiz farklılıklar – altını çiziyor Flavia FranconiUlusal Biyoyapılar ve Biyosistemler Enstitüsü Cinsiyet Tıbbı Laboratuvarı'ndan ve çalışmanın ortak yazarından elde edilen bu çalışma, hedefe yönelik antimikrobiyal yönetim müdahaleleri için bir başlangıç noktası olabilir”.
İdrar yolu enfeksiyonları: Doğru antibiyotiği bulmak altı saat sürebilir (iki gün değil)
kaydeden Anna Lisa Bonfranceschi
Direnç sorunu
Uygunsuz reçete yazma sorunu, günümüzde temel küresel sağlık acil durumlarından birini temsil eden antimikrobiyal direnç (AMR) olgusunun temelinde yatmaktadır. Bu sıralamada maalesef İtalya siyah gömleğiyle gösteriş yapıyor: 2024-2025'te ülkemizde 1000 kişi başına 22,3 günlük doz kaydedildi; AB ortalaması ise 20,3'tü.
İtalyanların yüzde 40'ı, özellikle kış aylarında (dolayısıyla grip virüsleri için) yılda en az bir antibiyotik reçetesi alıyor ve daha hedefe yönelik olanlara ihtiyaç duyulduğunda geniş spektrumlu antibiyotiklerin aşırı kullanımı var (Avrupa ortalamasının iki katı). Sonuçlar görülebilir: AIFA Raporundan elde edilen verilere ve 2025-2026 Avrupa ECDC merkezlerinin izlenmesine göre İtalya, dirençli bakterilere bağlı tüm Avrupa ölümlerinin %30'unu kaydediyor; her yıl yaklaşık 12 bin ölüm doğrudan çoklu dirençli bakterilerin neden olduğu enfeksiyonlardan kaynaklanıyor (toplamda yaklaşık 35 bin-40 bin). Bu ölümlerin en üst noktası hastanelerde, AMR ölümlerin yaklaşık üçte birinden sorumlu.
Her şeyden önce endişeleniyorum Klebsiella pneumoniaeAB ortalamasının (%13,3) iki katından fazla olan %26,5 oranlarıyla karbapenemlere dirençli, AsinetobaktAbruzzo gibi bazı bölgelerde direnç seviyeleri %90-97’ye ulaşan r ve meşhur Stafilokok aureusözellikle uzun süreli bakım tesislerinde direnç görülme sıklığı %26,6'dır.
Vakaların %68'inde antibiyotikler pratisyen hekimler tarafından reçete edilmektedir. Ancak Bölgeler belirli bir sıraya göre ilerlememektedir: Güney ve Adalar en yüksek değerleri kaydediyor ve genellikle ulusal ortalamayı %10-20 oranında aşıyor. Campania tarihsel olarak en yüksek tüketime sahip olan ülkedir ve Sicilya ve Basilicata da ortalamanın üzerinde tüketim göstermektedir. Tersine, daha az reçeteli ve daha düşük tüketimli Bölgeler, Kuzey'deki ve bazıları Merkez'deki bölgeler gibi görünmektedir: Avrupa ortalamasına daha yakın ilaç kullanımıyla daha erdemli olanlar, İtalya'nın genel olarak en az antibiyotiğin reçete edildiği bölgesi olan Bolzano PA, çok düşük reçete oranlarına sahip Friuli Venezia Giulia ve tüketimi ulusal ortalamanın biraz altında olan ancak yine de Avrupa uygunluk standartlarından uzak olan Toskana'dır.
Flavia Franconi, bu panoramada şöyle açıklıyor: “İtalya'da bu konuyla ilgili geniş çaplı bir ilk olan bir çalışmayla, doktor ve hastanın cinsiyetinin ve aralarındaki etkileşimin birinci basamakta antibiyotik reçeteleme kalıplarını etkileyip etkilemediğini ve nasıl etkilediğini araştırmak istedik.”
Tek hörgüçlü böceklerden gelen süper böceklere karşı yeni silahlar
Elisa Manacorda

Araştırma verileri
Çalışma, 2023 yılında 3 milyondan fazla hastadan oluşan bir kitle için 2.300'den fazla pratisyen hekimin antibiyotik reçetelerini analiz etti. Örneklemdeki doktorlar ortalama olarak erkek meslektaşlarından daha gençti (51'e karşı 58,6 yaş) ve biraz daha küçük bir hasta paneline sahipti. Hastaların %52,6'sı aynı cinsiyetten bir doktor tarafından takip ediliyordu.
Araştırmacılar, yaş, sosyoekonomik düzey ve yandaş hastalıkların yükü gibi değişkenleri de dikkate alarak doktorun cinsiyeti ile hastanın cinsiyetini eşleştirdiler. Analiz edilen üç ana gösterge, reçete edilen antibiyotik miktarı (DDD/1000 kişi/gün), antibiyotik reçetesi prevalansı, yani yıl içinde en az bir reçetesi olan hastaların yüzdesi ve “Erişim” reçeteleme oranı, yani WHO AWaRe sınıflandırmasına göre birinci basamak antibiyotiklerin yüzdesiydi.
Yazarların kendilerine göre çalışmanın bazı sınırlamaları vardır: Birincisi, reçetenin klinik endikasyonuna ilişkin verilerin bulunmaması ile temsil edilmektedir. Ayrıca reçetenin gerçekten dağıtılıp tüketilmediğini doğrulamanın imkansızlığı ve özel antibiyotik satın alımlarına (reçetesiz veya özel uzmanlar aracılığıyla) ilişkin veri eksikliği de mevcut.
Bu kritik sorunlara rağmen sonuçlar açık: Kadın doktorlar hem miktar hem de yaygınlık açısından erkek meslektaşlarına göre daha az antibiyotik yazıyor ve daha sıklıkla “Erişim” kategorisinden (yani daha uygun) antibiyotik yazıyorlar. Erkek meslektaşlar ortalama olarak günde 1000 kişi başına tanımlanmış günlük dozlardan neredeyse bir puan daha fazla reçete yazmaktadır. Mutlak rakamlara çevrilirse, Toskana'daki erkek doktorlar meslektaşlarına göre yılda yaklaşık 391 bin daha fazla doz reçete ediyor; bu da bölgesel toplamın %2,2 üzerinde.
Bu reçete yazma farklılıklarının etkisi erkek hastalar üzerinde daha belirgindir: Onlar için kadın doktora sahip olmak, erkek doktora sahip olmaya kıyasla antibiyotik reçetesi alma olasılığının önemli ölçüde daha düşük olduğu anlamına gelir.
Kateter ve stentlerden kaynaklanan enfeksiyonlar: Antibiyotik olmadan bakterileri %90 oranında azaltan İtalyan keşfi
kaydeden Irma D'Aria

Genç erkek doktorlar istisnası
Ancak resimde nüanslar yok değil. Doktorun yaşına göre sınıflandırma yapıldığında ilginç bir trend tersine dönüşü ortaya çıkıyor: 40 yaşın altındaki pratisyen hekimler arasında erkekler, özellikle kadın hastalara daha az antibiyotik yazıyor. Yazarların varsaydığı nesiller arasındaki fark, 2007'de pratisyen hekimlere yönelik, reçetelerin uygunluğu ve antimikrobiyal dirençle ilgili belirli kavramları içeren yapılandırılmış bir eğitim programının başlatılmasıyla bağlantılı olabilir.
Franconi, “Veriler, uzmanlık eğitiminin kuralcı davranışları şekillendirmede bir rolü olabileceğini öne sürüyor – ancak diğer kültürel ve ilişkisel faktörlerle karşılaştırıldığında eğitimin gerçekte ne kadar ağırlığa sahip olduğunu anlamak için daha fazla araştırmaya ihtiyaç var” diyor.
Kadın doktorlar neden daha az reçete yazıyor?
Yazarlar kesin açıklamalara girişmiyor ancak bilimsel literatür bazı ipuçları sunuyor. Önceki çalışmalar, doktorların özellikle üst solunum yolu enfeksiyonlarında antibiyotiklere başvurmadan önce “bekle ve gör” yaklaşımını benimseme olasılığının daha yüksek olduğunu göstermişti. Ek olarak, aynı cinsiyetten doktor-hasta iletişimi daha etkili olma eğilimindedir ve bu da hastanın reçete yazma baskısını azaltabilir.
Franconi, “Hasta ile doktor arasında daha iyi bir iletişim deneyiminin, kadın-kadın çiftlerinde gözlemlediğimiz olumlu etkileri en azından kısmen açıklayabileceği” sonucuna varıyor.
10 antibiyotiğe dirençli 5.000 yıllık bakteri bulundu
kaydeden Valeria Pini

Bir yanıt yazın